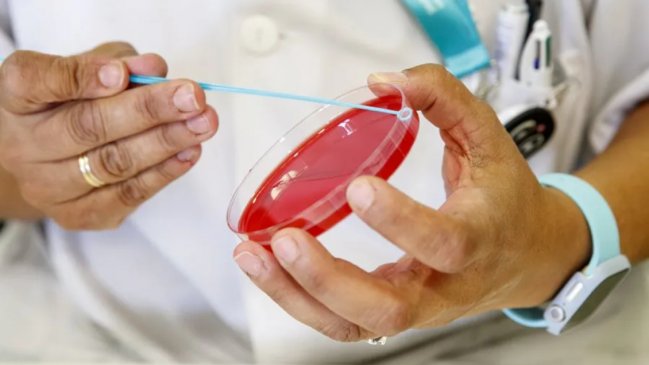

El Ministerio de Salud de Perú emitió este sábado una alerta epidemiológica regional en el departamento sureño de Puno por el riesgo de reintroducción de casos de sarampión importados de Bolivia, país con el que esta región comparte frontera.
A través de un comunicado, el Ministerio de Salud anunció que la Dirección Regional de Salud (Diresa) ha tomado esta decisión con el objetivo de intensificar la vigilancia epidemiológica y acciones de prevención en la región de Puno.
"Apenas se conoció el inicio del brote en Bolivia, la Diresa reforzó la vigilancia activa, así como la supervisión y vacunación en puntos de entrada y establecimientos de salud, por lo que la alerta epidemiológica busca dar un mayor impulso no solo en zonas de frontera sino en toda la región", indicó el mensaje.
Según cifras del Ministerio de Salud y Deportes de Bolivia, al 17 de julio, este país reporta 125 casos de sarampión, 104 en Santa Cruz, 10 en La Paz, 4 en Potosí, 3 en Beni, 2 en Chuquisaca, 1 en Oruro y 1 en Pando.
"Las autoridades de salud exhortan a toda la población, especialmente a quienes hayan retornado recientemente de Bolivia, a estar atentos ante cualquier síntoma de fiebre, erupción en la piel o cuadro respiratorio", señala la información.
La cartera peruana precisó que los centros de salud de Puno han sido abastecidos con 44.750 dosis de vacunas contra el sarampión, para que la población cumpla con el esquema de dosis infantil y así evitar brotes y proteger a los menores.
El Ministerio recordó a la población que la vacuna es gratuita, segura y eficaz; y se aplica en dos dosis, la primera a los 12 meses y la segunda a los 18 meses.
Así mismo, la Diresa reportó que se han establecido seis puntos de vacunación en zonas de frontera con Bolivia: en Tilali, en la provincia de Moho; en Kasani, Anapia y Tinicachi, en la provincia de Yunguyo y en Carancas, en la provincia de Chucuito.
Finalmente, en el distrito de Desaguadero, la vacunación se realiza de manera permanente y se intensifica los martes y viernes.